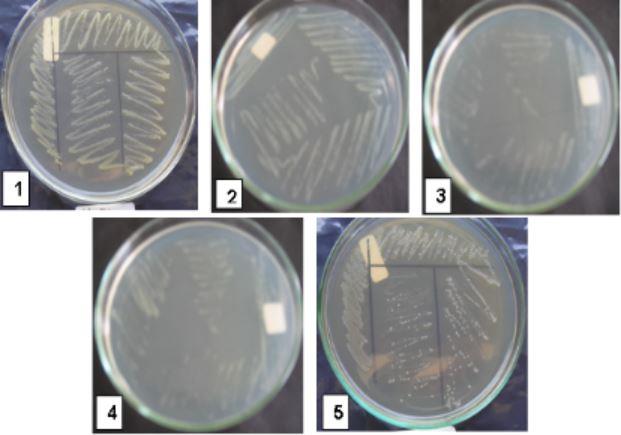
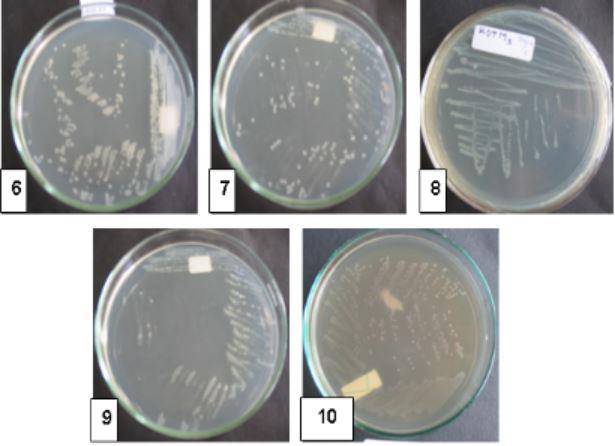

Kelompok Penelitian Rekayasa Sumberdaya Perairan Darat
- Drs. Tjandra Chrismadha, M.Phill. (Ketua)
- Dra. Djamhuriyah S. Said, M.Si.
- Dr. Ir. Fauzan A.
- Dr. Tri Widiyanto, M.Si.
- Dr. Livia Rossila
- Triyanto, S.Pi, M.Si
- Nina Hermayani Sadi, M.Si
- Novi Mayasari, S.Pi., M.Si.
- Sekar Larashati, M.Si., Ph.D.
- Miratul Maghfiroh S.TP, M.S
Perairan darat beserta lingkungannya merupakan satu ekosistem yang di dalamnya
terdiri dari komponen-komponen ekosistem yang secara integratif menyelenggarakan
fungsi-fungsi ekosistem. Komponen-komponen ini meliputi komponen biologis, yaitu
kekayaan biota di dalam perairan danau, serta komponen fisika-kimia, seperti geologi,
klimatologi, hidrologi, sedimen, dan lain sebagainya. Antar komponen dalam ekosistem
saling berinteraksi dalam bentuk proses-proses ekologis yang secara langsung maupun
tidak langsung berkaitan dengan siklus-siklus materi dan energi di dalamnya. Proses-proses
ekologis menentukan keberlangsungan fungsi-fungsi ekosistem perairan darat, yaitu
sebagai sumber air, habitat, dan siklus nutrien.
Upaya pengembangan teknologi didasarkan pada pengenalan komponen utama yang mengendalikan
fungsi dan mensimulasikan kondisi ekosistem dengan memanfaatkan komponen utama tersebut sebagai instrumen pengendali untuk revitalisasi fungsi tertentu tadi. Beberapa litbang yang telah dilakukan disajikan di bawah ini.
Peningkatan Produktivitas Kultur Mikroalga Menggunakan Fotoreaktor Tubular
Mikroalga dalam ekosistem perairan darat merupakan komponen biotik yang banyak
ditemukan sebagai fitoplankton, dan berperan penting sebagai produsen primer.
Berbagai hasil penelitian telah mengemukakan potensi pemanfaatan kelompok mikroorganisme
ini, khususnya untuk keperluan pakan dan pangan fungsional, yaitu sebagai biomassa
pakan larva ikan dan udang, sumber protein, dan sumber berbagai bahan kimia, seperti
antioksidan dan asam lemak tak jenuh. Meskipun demikian, upaya produksi mikroalga
secara besar-besaran belum berhasil dilakukan, terutama terkendala dengan tingkat
produktivitas biomassa yang rendah akibat keterbatasan penetrasi cahaya pada kolom
media kulturnya.

Alga biru Spirulina, sistem kultur fotobioreaktor tubular, dan pengolahan biomassanya
(Foto: T. Chrismadha).
Apartemen Udang Galah, Lebih Nyaman Dan Lebih Produktif
Tingginya harga udang komersial yang beredar di pasaran, serta kebutuhan akan
adanya pasokan protein ikan alternatif mendorong penelitian dalam budidaya udang
galah. Udang galah (Macrobrachium rosenbergii) diketahui mengandung kadar protein
yang tinggi (60-70 %) dan rasa yang tidak kalah dengan dari udang komersial lainnya,
seperti udang windu. Selama ini udang galah dikonsumsi masyarakat dengan menangkapnya
dari perairan alaminya seperti sungai-sungai di Kalimantan, Sumatera Selatan,
Jambi, Riau, dan Sulawesi. Di Jawa, populasinya di alam sudah sangat berkurang
karena tekanan aktivitas manusia terhadap lingkungan hidupnya. Karenanya, budidaya
udang galah di masyarakat makin lama makin berkembang, walaupun produksinya masih
relatif rendah. Teknologi budidaya seperti reproduksi, manajemen kualitas air,
manajemen kolam dan pakan masih memerlukan kajian melalui penelitian.

Desain kolam arus deras dan apartemen udang galah (Foto: T. Chrismadha).
Upaya meningkatkan produktivitas budidaya udang galah di Puslit Limnologi LIPI
telah dilakukan melalui pendekatan kesesuaian habitat dan efisiensi ruang. Kesesuaian
habitat didekati dengan konsep kolam arus deras dengan kesuburan air terkontrol
(Ali dkk., 2002). Hal ini sesuai dengan habitat alami udang galah yang banyak
hidup di lingkungan perairan sungai. Sementara itu efisiensi ruang didekati dengan
konsep stratifikasi substrat tumbuh dengan menyediakan tempat pijakan berlapis
yang kemudian lebih dikenal sebagai apartemen udang.

Aplikasi teknologi apartemen di kolam masyarakat Kabupaten Bogor (Foto: T. Chrismadha
& F. Ali).
Aplikasi Bioremediasi Pada Tambak
Pada dekade tahun 1980-an udang windu merupakan komoditas ekspor non migas yang
sangat menguntungkan, akan tetapi saat ini kondisinya sangat memprihatinkan. Berjuta
hektar lahan tambak disepanjang pantura merana dan terlantar. Secara teoritis
pengontrolan dan pengendalian senyawa metabolit toksik hanya dapat dilakukan dengan
melalui aktivitas biologis yang banyak dilakukan oleh kelompok mikroorganisme
(bakteri). Hal inilah yang mendorong dikembangkannya penelitian dan pengkajian tentang metode bioremediasi untuk mengontrol terjaganya tingkat kualitas
air yang dibutuhkan dalam usaha budidaya udang windu. Metode bioremediasi yang
dikembangkan adalah dengan memanfaatkan aktivitas bakteri nitrifikasi dan denitrifikasi
indegenous yang berasal dari sistem tambak itu sendiri (Widiyanto dkk., 2006).
Beberapa isolat bakteri telah berhasil diisolasi dan diseleksi skala laboratorium
serta uji lapangan untuk pengendalian kualitas air tambak memberikan hasil yang
baik, khususnya yang terkait dengan daur nitrogen dan kandungan oksigen terlarut.
|
|
Isolat bakteri nitrifikasi dan denitrifkasi hasil seleksi (Foto: T. Widiyanto).
 |
 |
Persiapan inokulem bakteri agen bioremediasi (Foto: T. Widiyanto).
 |
 |
Udang hasil Uji Coba Metode Bioremediasi Skala Pilot di Karawang Jawa Barat (Foto:
T. Widiyanto).
Pengembangan Kanal Perifiton Untuk Pengendalian Limbah
Perifiton merupakan sekelompok mikroorganisme autotrofik didominasi oleh mikroalga
berasosiasi dengan bakteri, jamur dan mikro fauna lainnya, hidup berkoloni dan
menempel pada benda padat di zona bentik suatu perairan. Selain produsen primer
utama pada ekosistem lotik, perifiton juga merupakan indikator yang sangat tepat
untuk menentukan kondisi ekologis dan pencemaran suatu perairan. Beberapa keunikan
mikroorganisme ini diantaranya, perifiton dapat tumbuh pada kondisi cahaya dan
nutrient yang terbatas, hidupnya sangat dipengaruhi oleh suhu, komunitas perifiton
mampu dengan cepat menyerap nutrisi di badan air dan tumbuh dengan populasi yang
bervariasi dalam spesies. Pertumbuhan populasi yang berlebihan perifiton ini dapat
terjadi di alam atau di kanal yang mengalami peningkatan suhu dan kurangnya pengelolaan
arus atau kelebihan nutrien pada daerah padat penduduk, aliran pada fasilitas
pengolahan air limbah, kawasan pertanian, penggundulan hutan dan gangguan tanah
lainnya.

Fotobioreaktor kanal perifiton (Foto: Nofdianto).

Aplikasi kanal perifiton pada sistem aquakultur (Foto: Nofdianto).

Tubular-Fotobioreaktor perifiton (Foto: Nofdianto).

Model kanal perifiton uptake logam berat (Foto: Nofdianto).
Pemanfaatan Tumbuhan Air Terapung untuk Pakan dan Kontrol Kualitas Air pada Budidaya Perikanan
Pakan dan kualitas air merupakan kendala utama dalam usaha budidaya perikanan.
Kedua permasalahan tersebut dapat diatasi secara terpadu dengan memanfaatkan tumbuhan
air yang berfungsi ganda, yaitu sebagai fitoremediator kualitas air dan sumber
pakan alami. Pengembangan teknologi budidaya perikanan terpadu ini telah dilakukan
di Puslit Limnologi mulai tahun 2011 sampai dengan sekarang. Tumbuhan air yang
dipilih adalah jenis mata lele (Lemna perpusilla Torr.), yang telah diketahui
tumbuh kosmopolit di perairan tropis termasuk di Indonesia.

Satu rumpun lemna (kiri) dan ‘root sheath’ dan ‘venae’ sebagai penciri jenis Lemna perpusilla Torr (Foto: T. Chrismadha).

Kultur massal lemna di Puslit Limnologi LIPI Cibinong (Foto: T. Chrismadha).

Biomassa kering lemna bisa disimpan lama (Foto: T. Chrismadha).
Pengembangan Akuaponik Memanfaatkan Media Limbah Perikanan
Akuaponik merupakan sebuah hasil perkawinan antara teknologi akuakultur dan agrikultur, yakni menggunakan limbah ikan yang mengandung semua nutrisi yang diperlukan untuk pertumbuhan tanaman secara optimal. Akuaponik menggunakan tanaman dan media di mana mereka tumbuh untuk membersihkan dan memurnikan air, setelah itu dikembalikan ke tangki ikan. Air ini dapat digunakan kembali tanpa batas waktu dan hanya perlu diganti bila hilang akibat transpirasi dan evaporasi. Siklus nitrogen pada system akuaponik dimulai dengan masuknya protein melalui pakan dan ekskresi ikan untuk membentuk total amonia nitrogen (TAN) dalam sirkulasi air. Amonia (NH3) kemudian dikonversi menjadi nitrat (NO3) oleh bakteri nitrifikasi (Nitrosomonas spp., dan Nitrobacter spp.). Ammonium (NH4+) dan NO3 selanjutnya diambil oleh tanaman, dan dua hasil panen (tanaman dan ikan) yang diperoleh dari sistem.

Pengembangan Akuaponik di Pusat Penelitian Limnologi-LIPI Cibinong (Foto: Nofdianto).
Peningkatan Kualitas Pada Ikan Hias
Indonesia memiliki sumber daya ikan hias jenis asli maupun endemis seperti ikan-ikan
pelangi baik yang dari Papua maupun Sulawesi., ikan dari Sumatra seperti ikan
botia, ikan sumatra, ikan bada. Ikan-ikan tersebut memiliki ukuran tubuh yang memadai dan beraneka warna yang memikat para penggemar ikan hias. Keindahan yang ditampilkannya
terutama pada jenis kelamin jantan dan umumnya jenis kelamin jantan lebih disenangi
karena di samping keindahan warna, juga gerakannya yang lebih atraktif. Umumnya bersifat schooling fish sehingga memberikan keunikan tersendiri terutama saat ikan ini
berada dalam akuarium. Akan tetapi kondisi yang dihadapi bahwa jumlah individu
ikan jantan selalu lebih kecil daripada individu betina, pertumbuhan yang relatif
lambat, ketahan hidup yang rendah, dan juga reproduksi yang belum optimal.
Untuk mengantisipasi masalah-masalah tersebut Pusat Penelitian Limnologi melakukan
beberapa penelitian untuk peningkatan kualitas ikan hias asli/endemis, seperti
melakukan hibridisasi untuk meningkatkan jumlah individu ikan berkelamin jantan.
Penelitian juga dilakukan mendapatkan informasi kesesuain pakan untuk reproduksi,
pertumbuhan, dan keindahan penampilan warna, kesesuaian lingkungan untuk pertumbuhan
optimum, dan juga kondisi biologis lainnya seperti rasio kelamin dalam bereproduksi.
 |
 |

|
Melanotaenia praecox Glossolepis incisus Melanotaenia boesemani



Chromobotia macracanthus Puntius tetrazona (Green) Marosatherina ladigesi

Contoh Kombinasi pasangan induk ikan pelangi dan hibrida terpilih (Sumber: D.S.
Said).
Sumber: Buku Tiga Dasawarsa Berkarya Pusat Penelitian Limnologi LIPI. Lukman
dkk. 2017. LIPI Press.














 reading Puslit Limnologi LIPI
reading Puslit Limnologi LIPI






